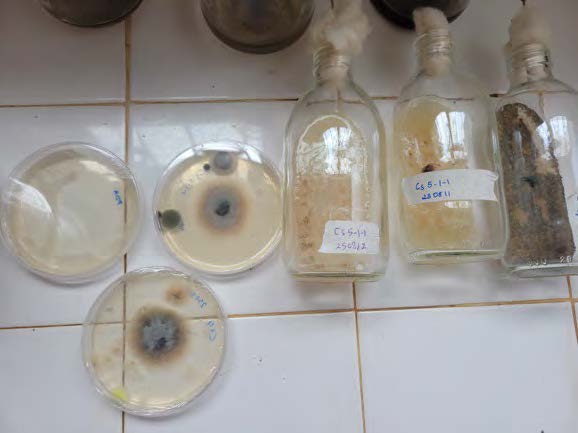

Business Trip to Madagascar–Output2, The University of Tokyo JSPS Postdoctoral Fellow, Yuniar Devi Utami
Dr. Yuniar Devi Utami, JSPS Postdoctoral Fellow at the University of Tokyo and a member of SATREPS ValyAla Project Output 2, traveled to Madagascar in August to conduct inoculation trials using selected filamentous fungi.
She visited the Centre National de la Recherche sur l’Environnement (CNRE) and provided guidance on maintaining fungal materials and on procedures for soil inoculation. She also visited the Antsirabe region with her Malagasy counterparts to identify potential field trial sites and to discuss the trial plan with landowners.